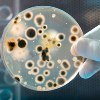

Другие названия и синонимы
Sputum seeding on flora with sensitivity determination.
Описание
Посев мокроты на микрофлору с определением чувствительности к антибиотикам. Бактериологическое исследование бронхиального секрета с целью выявления микробных или других агентов и выбора рациональной антимикробной терапии. Посев мокроты на микрофлору назначают при пневмонии, абсцессе легкого, бронхоэктазии, бронхите Боли в спине мокроты следует проводить до начала антибактериальной терапии, чтобы избежать ложноотрицательного результата. Одна порция мокроты собирается натощак после того, как полость рта реорганизована в стерильный контейнер с плотной крышкой. Интерпретация полученных результатов содержит заключение о наличии или отсутствии роста, количестве микроорганизмов, их форме, чувствительности и устойчивости к антибактериальным препаратам.
|
|
Номенклатурные коды
- A26.09.004 Микробиологическое (культуральное) исследование бронхоальвеолярной жидкости на микобактерии туберкулеза (Mycobacterium tuberculosis complex)
- A26.09.013 Микробиологическое (культуральное) исследование мокроты абсцессов на неспорообразующие анаэробные микроорганизмы
- A26.09.010 Микробиологическое (культуральное) исследование мокроты на аэробные и факультативно-анаэробные микроорганизмы
- A26.09.026 Микробиологическое (культуральное) исследование мокроты на криптококк (Cryptococcus spp.)
- A26.09.002 Микробиологическое (культуральное) исследование мокроты на микобактерии туберкулеза (Mycobacterium tuberculosis complex)
- A26.09.006 Микробиологическое (культуральное) исследование мокроты на микоплазму (Mycoplasma pneumoniae)
- A26.09.016 Микробиологическое (культуральное) исследование мокроты на хламидии (Chlamidia pneumoniae)
- A26.08.005 Микробиологическое (культуральное) исследование слизи с миндалин и задней стенки глотки на аэробные и факультативно-анаэробные микроорганизмы
- A08.30.046.008 Оценка, интерпретация и описание результатов патолого-анатомического исследования биопсийного (операционного) материала третьей категории сложности